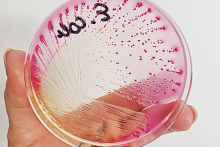
Dłoń w rękawiczce trzyma szalkę Petriego z różowym podłożem. Na powierzchni widać liczne kolonie bakterii w odcieniach różu i fioletu, ułożone w liniach rozchodzących się promieniście. Na górze szalki widnieje czarny napis „3”.

Co przygotował Wydział Nauk o Zdrowiu
Wydział Nauk o Zdrowiu włącza się w organizację Festiwalu Nauki co roku, a całość koordynuje dr hab. Małgorzata Witkowska z Zakładu Anatomii Człowieka, członkini Rady Programowej FN.
Warsztaty dla wszystkich zainteresowanych
Tym razem nasi naukowcy przygotowali i poprowadzili siedem warsztatów – były otwarte dla wszystkich, niektóre wymagały tylko wcześniejszych zapisów. Tematyka - bardzo zróżnicowana i aktualna.
Dr hab. Agnieszka Bzikowska-Jura oraz mgr Aleksandra Mołas z Zakładu Biologii Medycznej poprowadziły warsztat "Mleko kobiece pod lupą – nauka i praktyka na podstawie działalności Banków Mleka Kobiecego". Zajęcia odbywały się w Banku Mleka Kobiecego w Szpitalu im. Świętej Rodziny w Warszawie, były więc okazją do sprawdzenia, jak od podszewki działa taka instytucja. Uczestnicy warsztatu poznali także metody badań laboratoryjnych stosowanych w bankach mleka oraz analizowali próbki mleka kobiecego.
Dr hab. Grażyna Bączek, kierownik Zakładu Dydaktyki Ginekologiczno-Położniczej zaprosiła na prezentację multimedialną na temat zdrowia prokreacyjnego, ciąży, porodu, połogu, rozwoju człowieka, pielęgnowania noworodka i karmienie piersią. Natomiast dr Agnieszka Iwan z Zakładu Dydaktyki Ginekologiczno-Położniczej przy współpracy z Oddziałem Uniwersyteckiego Polskiego Towarzystwa Położnych zaprezentowała przegląd nowoczesnych aplikacji wspierających kobiety przed ciążą, w ciąży i w połogu. O nowoczesnych technologiach w medycynie mówili też: dr hab. inż. Antoni Grzanka, dr inż. Radosław Roszczyk (PW, EMBS IEEE) i Klaudia Malicka podczas warsztatu "Technologie medyczne przyszłości – jak inżynieria zmienia opiekę zdrowotną".
Okazją do eksperymentów były zajęcia dotyczące technik mikrobiologicznych prowadzone przez dr Sylwię Jarzynkę i dr Annę Minkiewicz-Zochniak z Zakładu Biologii Medycznej oraz przez studentów SKN AGAR. Cieszyły się dużym zainteresowaniem wśród młodzieży.
Eksperci WNoZ przygotowali też warsztat dla przyszłych babć i dziadków. Tu uczestnicy mogli się dowiedzieć, jak obecnie wygląda poród, jakie są nowe trendy w opiece okołoporodowej, jak opiekować się maluchem i jego mamą, jak rozmawiać z młodymi rodzicami, żeby chcieli słuchać i nie czuli się przytłoczeni… Zajęcia przygotowali: dr hab. Małgorzata Stefaniak, dr Aleksandra Geller, Aleksandra Celuch z Zakładu Dydaktyki Ginekologiczno-Położniczej wraz ze Studenckim Kołem Naukowym Etyki.
Od zajęć anatomicznych do profilaktyki raka piersi - lekcje festiwalowe
W ramach Festiwalu Nauki WNoZ zorganizował również festiwalowe lekcje dla szkół. Licealiści mogli wybierać spośród następujących zajęć:
- „Co w tkankach piszczy?”, w czasie których mogli zwizualizować tkanki miękkie własnego organizmu i zmierzyć prędkość przepływu krwi w naczyniach krwionośnych. Lekcję poprowadzili: dr Paweł Kowalczyk i dr hab. Anna Henriques de Sepulveda;
- „Tajemnice ludzkiego ciała”, które były lekcją anatomii z wykorzystaniem wirtualnego stołu anatomicznego. Poprowadzili ją: dr Tomasz Piątek i dr Marta Hreńczuk;
- „Rozwój i narodziny człowieka”, w czasie których dowiedzieli się, jak wygląda poczęcie, rozwój wewnątrzmaciczny i narodziny człowieka z punktu widzenia biologii, fizjologii, psychologii i socjologii. Lekcję poprowadziła: dr hab. Grażyna Bączek;
- „Poznaj, zbadaj, chroń”, w czasie których poznali tajniki profilaktyki raka piersi. Lekcję poprowadziły: prof. Anna Badowska-Kozakiewicz, studentki: Kamila Krupa i Hanna Miski;
- „Serce i krew bez tajemnic”, w czasie której dowiedzieli się, czym jest badanie EKG oraz „rozłożyli” na czynniki pierwsze skład morfotyczny krwi. Lekcję poprowadzili: dr Edyta Wróbel i dr Paweł Kowalczyk;
- „Bandażowy challange”, w czasie których mogli opanować podstawowe technik bandażowania. Lekcje poprowadzili: dr Tomasz Piątek i dr Marta Hreńczuk.
Co się działo na Wydziale Farmaceutycznym
Warsztat otwarty o monitoringu glikemii
Uczestnicy festiwalu mogli wziąć udział w warsztacie "Słodki problem - stały monitoring glikemii jako element opieki nad pacjentem diabetologicznym". Temat ważny, bo w Polsce stale przybywa pacjentów chorych na cukrzycę, a choroba jest uznawana przez WHO za epidemię XXI wieku. Samokontrola zaś to integralna część leczenia tej jednostki chorobowej. Prowadząca warsztat mgr Sylwie Lewandowska-Pachecka zaprezentowała uczestnikom warsztatów zasady systemów monitorowania glikemii metodą skanowania (flash glucose monitoring) i ciągłego monitorowanie glikemii (continuous glucose monitoring), dzięki którym pacjent otrzymuje informację, jak należy modyfikować wielkość i rodzaj posiłków oraz w jakim stopniu aktywność fizyczna wpływa na utrzymanie prawidłowych parametrów.
Zajęcia dla uczniów w laboratoriach
Dla uczniów – zarówno szkół średnich, jak i podstawowych - wydział zorganizował aż pięć różnych lekcji festiwalowych.
Dr Natalia Dobros i dr hab. Katarzyna Paradowska zgłębiły tajemnice antocyjanów, czyli naturalnych barwników o szerokich właściwościach prozdrowotnych, które występują w warzywach i owocach. Opowiedziały od czego zależy barwa antocyjanów, pokazały jak oznaczać ich całkowitą zawartość w produktach oraz jak określać ich właściwości antyoksydacyjne. Prowadzące wyjaśniły również, czym są wolne rodniki i jak niwelować ich nadmiar z organizmu.
W czasie warsztatów „Witamina C pod lupą” uczniowie dowiedzieli się, z czego składa się witamina C, jaka jest jej zawartości w różnych pokarmach, jakie są jej właściwości antyoksydacyjne oraz jakie ma znaczenia dla zdrowia człowieka. Warsztaty były skierowane do licealistów, a ich celem, oprócz przygotowania uczniów do samodzielnej weryfikacji nieprawdziwych wiadomości dotyczących witaminy C, było także utrwalenie wiadomości dotyczących reakcji redoks, szczególnie reakcji barwnych, które występują w zadaniach maturalnych. Swoją wiedzą podzieliła się dr Ewa Szyp-Sochacka.
O tym, jak magiczna i kolorowa jest nauka przekonywały dr Sylwia Michorowska i mgr Agnieszka Kalicka w czasie warsztatów „Tęczowe Eksperymenty: Magia światła i kolorów!”. Skąd biorą się kolory? Dlaczego niektóre substancje są barwne jak tęcza, a inne zmieniają barwy niczym za dotknięciem czarodziejskiej różdżki? Na te pytania, pod czujnym okiem prowadzących, szukali odpowiedzi uczniowie szkół podstawowych. Sprawdzali, jak domowe składniki mogą zmieniać kolory, tworzyli barwne osady i przekonywali się, jak światło wpływa na to, co widzimy.
Z kolei dr hab. Kinga Ostrowska i dr Mariusz Dana demonstrowali, jak działają leki i skąd biorą się substancje czynne, a także jak wygląda ich synteza w laboratorium. W czasie warsztatu uczniowie mogli poczuć się jak prawdziwi chemicy! Poznali tajniki budowy i działania substancji czynnych w lekach, krok po kroku zsyntetyzowali wybrany związek aktywny oraz przeprowadzali izolację naturalnych substancji z surowców roślinnych.